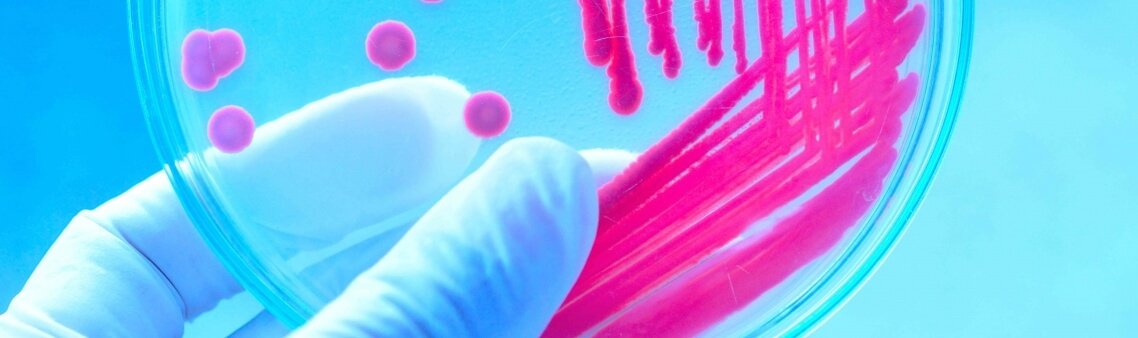
Analisis Superficies Laboratorio Especializado Siggo

Analisis De Covid 19 En Superficies Proinca Consultores

Analisis De Superficies Para Deteccion De Covid 19 Grupo Ivac Ivac Instituto

Canatec 35 Analisis De Aguas Y Alimentos Laboratorio Analisis Microbiologico De Superficies De Trabajo


Analisis Microbiologicos Para Superficies Vivas Seidlaboratory
Microbiologia De Superficies Ambientes Y Manipuladores Laboratorio Aide

Analisis De Superficies Quinolab Sas
Analisis Superficies Laboratorio Especializado Siggo
Hse Ingenieria Por Que Es Importante Realizar Analisis De Superficies Vivas E Inertes Los Microorganismos Patogenos Pueden Pasar De Un Alimento A Otro Por Contacto Directo A Traves De Quienes Los
Analisis Microbiologico De Superficies Y Ambiente Laboratorios Lancen

Analisis De Superficie Viva E Inerte Inocuolab

Analisis De Superficie

